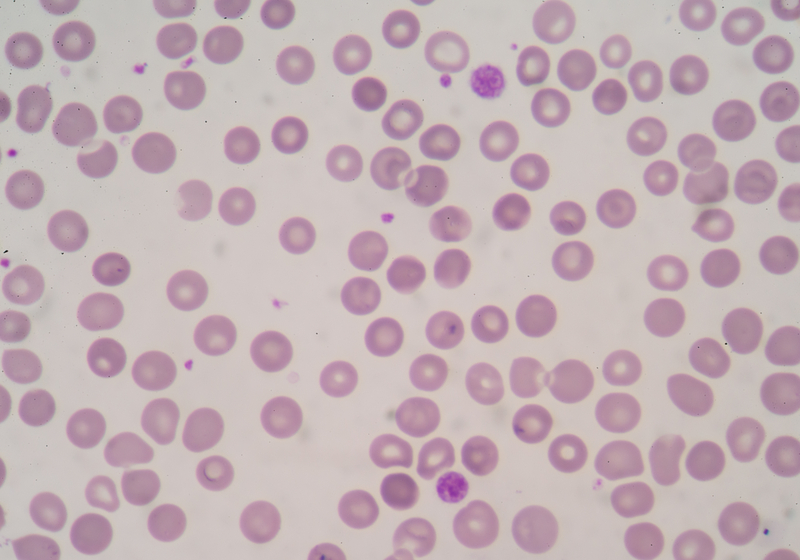

The Most Common Symptoms of Inflammatory Disease
Inflammation is one of the body’s natural defenses against infections from bacteria, viruses, and other invaders. Inflammation is usually a process in which the body produces and deploys white blood cells to flush out and destroy any foreign bodies in the bloodstream. However, there are certain conditions or situations in which the body can trigger inflammatory responses without any invaders being present. These conditions are known as inflammatory diseases and affect millions of individuals around the world. Learn more now about the common signs and symptoms indicating that an individual may be dealing with an inflammatory disease.
Swelling

One of the most common symptoms of inflammation is the swelling of body parts, usually seen in the extremities, such as the legs, arms, feet, and hands. As the body produces an overabundance of white blood cells, the fluids associated with these cells will need to pool somewhere, usually within the extremities. In some cases, if the joints become swollen, they can also become warm to the touch, such as what some patients experience with arthritis. To reduce symptoms consider using an anti-inflammatory cream. Due to gravity, the most common body parts to swell due to inflammatory diseases are the feet. If a patient experiences frequent swelling of their feet, they should consult with their doctor and schedule a screening for inflammatory diseases.
Continue reading to find out another common symptom of inflammatory disease: back or neck pain.
Back Or Neck Pain

The swelling caused by inflammatory diseases is not just limited to the hands and feet. Sometimes fluids can build up in other areas such as the lower back, the neck, or the shoulders. One of the most common complaints doctors hear about is neck and shoulder pain. While this is most often assumed to be lifestyle or stress-related tension, certain inflammatory diseases can cause chronic neck and back pain, such as arthritis. In some instances, swelling in the neck, back, or shoulders can lead to joint pain and stiffness, and even the loss of joint function. To prevent and treat pain usePenetrexand a lower back belt. If an individual has tried all the remedies that they can find but still have a sore back or neck, they should ask their doctor about inflammatory diseases and if they are possibly afflicted with it.
Keep reading to learn about other typical body parts that can become swollen and stiff.
Sore Feet Or Hands

The swelling associated with inflammatory disease, known as edema, most commonly affects the hands and feet in a majority of patients. While this can become extreme, and lead to visibly swollen and engorged appendages, sometimes the swelling can be mild to moderate and not visible to the naked eye, but nonetheless painful for the patient. People suffering from edema can use compression socks to relieve pain. This type of swelling results in soreness, however, chronically sore hands and feet could be a sign that an individual is suffering from a mild inflammatory disease. If pain medication does not provide any relief from the pain, a person may more than likely be suffering from inflammation caused by an inflammatory disease.
Next, learn about the surprising symptoms that are associated with inflammation that many individuals may not be aware of.
Flu-like Symptoms

In many cases, inflammatory diseases do not present any of the usual swelling-related symptoms most individuals know of when it comes to inflammation. Inflammatory diseases can sometimes cause more generalized symptoms that are often associated with the flu such as headaches, fatigue, chills, a loss of energy or appetite, and muscle stiffness. If a patient constantly suffers from any of these symptoms but are otherwise healthy, this could indicate that they have a mild inflammatory disease. Patients should consult with their doctor to be assessed.
Continue reading to learn about joint pain and causes behind it.
Joint Pain

Many types of joint pain are caused by inflammatory diseases. The extra fluid that can build up as a result of an inflammatory disease can put an incredible amount of pressure on the joints, resulting in pain or tenderness that can be warm to the touch. Multiple types of arthritis’ are associated with inflammatory diseases, such as rheumatoid arthritis, psoriatic arthritis, and gouty arthritis. As with all of the symptoms on this list and if a patient is at risk for developing an inflammatory disease, such as arthritis, due to lifestyle, environmental, or hereditary factors, they should talk to their doctor if they believe they are afflicted with arthritis or another inflammatory disease.
Next, discover how mood swings and depression are connected to inflammatory diseases.
Mood Swings Or Depression

First of all, not all cases of depression or mood swings are the result of inflammation or an associated condition. However, inflammation can cause these symptoms to appear in some individuals. A study from the Emory School of Medicine hypothesized that even minor increases in inflammation could cause an increase in depression and mood swings. Researchers who medically induced inflammation in their patients, for instance with chemotherapy, have also found this hypothesis to be correct. The study also found that individuals with heart disease who are depressed will often have higher inflammation levels within their body. Many studies show that a combination of exercise and fatty acids, such as Omega-3 found in salmon, can reduce inflammation and consequently reduce bouts of depression and mood swings.
Keep reading to reveal an interesting symptom that many patients may not be aware of.
Itchy Skin

Itchiness and redness of the skin is a prevalent symptom of inflammation in the body. This type of sign can be caused by allergies, inflammation diseases, or even an inefficient liver. If the liver is inflamed, it will produce significant amounts of a chemical that is a reactive protein, that can cause itchiness and redness in the skin. Inflammatory disease is the most common ailment in the field of dermatology. Skin inflammation will come in forms such as rashes, skin itching, redness, and even chronic conditions such as eczema, dermatitis, rosacea, and psoriasis. The skin can become itchy and inflamed due to allergies or exposure to a triggering stimulant, and the body will produce inflammatory hormones, causing this symptom. Itchy skin is also quite common in those with hepatitis, and if any itchiness or redness persists, a patient should see a health professional as soon as possible.
Next, find out how stomach pain can be the result of an inflammatory disease.
Gastrointestinal Issues, Lower Abdomen & Pelvic Pain

The two main ways to remedy inflammation in the gastrointestinal region are through diet and by maintaining a healthy weight. Diet and weight can both cause inflammation in the stomach and gastrointestinal tract, and the pain that is associated with this can be incredibly intense. Issues can arise within the digestive system due to inflammation such as acid reflux, bloating, constipation, and diarrhea. Diets rich in fruit, healthy fats, nuts, proteins, and seeds are ideal. Individuals dealing with stomach inflammation should avoid packaged and processed foods, as it can irritate the delicate lining of the digestive tract. A healthy weight is also greatly important in controlling inflammation in the body.
Continue reading to learn the risks associated with chronic inflammation.
The Risks Of Chronic Inflammation

Not only can inflammation become incredibly painful as well as an annoyance, but it can also affect the body in various damaging ways. Heart and cardiovascular disease have been linked to chronic inflammation, as a study from Stanford University found that the coronary artery disease risk may be connected to the internal genes associated with inflammation. If the lungs are inflamed, many complications can also arise. Asthma, chronic obstructive pulmonary disease, including bronchitis and emphysema, and infections may develop if the lungs are affected by inflammation.
Not to mention that if the lungs are inflamed, fluid will accumulate, making it difficult for the patient to breathe. Lastly, those with chronic inflammation should be aware that there is an increased risk of bone density loss and a lack of bone growth associated with this condition. A study in the Journal of Endocrinology somewhat proved this theory and the lack of bone density and the increased risk is due to cytokines, which is a substance the body releases to deal with an infection, within the bloodstream.
Keep reading to learn how persistent symptoms are a constant battle for anyone dealing with an inflammatory disease.
Persistent Symptoms

Persistent symptoms are common in those suffering from chronic inflammation, which is usually classified as low-grade. Persistent inflammation has been linked to a myriad of conditions, including heart disease and asthma, and can be caused by environmental and habitual factors. Pollution or a poor diet and exercise regime can also cause persistent inflammation. An anti-inflammatory diet is often recommended for those with low-grade, chronic inflammation as well as those with arthritis. Inflammation is the body's natural response to an internal problem, whether it is real or not, and it can also make individuals aware of other issues within their body.
Finally, discover what causes these numerous signs and symptoms of inflammatory diseases and its effects on the body.
What Causes These Symptoms?
Inflammatory diseases will prompt the body to send an inflammatory response to an internal threat, even if no real risk exists. These white blood cells now have nowhere to go, and sometimes they can also act aggressively towards organs or other cells and tissue. Specifically, the chemicals from the body’s white blood cells are released into the bloodstream or the affected tissues to protect the body from foreign substances. This release of chemicals increases the blood flow to the area that is affected by an injury or infection and can result in the area becoming red and warm. Some of these bodily chemicals cause a leak of fluid into the tissues, which results in that body part becoming swollen. Considered a protective process, this process can stimulate the nerves and cause intense pain for some individuals. With the increased number of cells and inflammatory substances within the joint or affected area, this causes irritation, swelling of the joint lining, and can eventually wear down and deteriorate the cartilage within the joint.